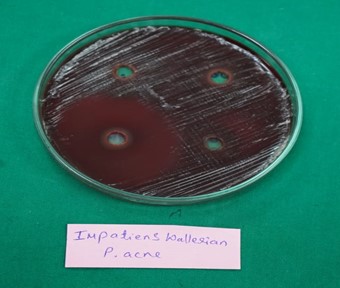

Abstract
Herbal medicines from plants are being increasingly used to treat a number of ailments and numberof culinary herbs have been evaluated for their beneficial effects in the management of ailments. Plant based antiacne are in demand for its cosmetic or pharma industry. In pursuit of finding such safe drug presents antiacne activity employing a hydro alcoholic extract of plant namely Impatiens walleriana .Antiacne effect of Impatienswalleriana species is not reported, present study was undertaken to investigate the antiacne effect on gram positive organisms. The effect of 50mg/ml, 100mg/ml and 200mg/ml of the hydroalcoholic extract on gram +ve organisms has been tested using the disc diffusion method. Finding confirmed the antiacne potential as the organism used in the study were hydroalcoholic extract.Further phytochemical studies reveal the presence of proteins, phenolics, tannins, steroids and flavonoids. The observed antiacne activity could be attributed to the presence of any of theseor synergistic effect due to these constituents. Ethnopharmacological claim for using this plant to treat thesevereacne is substantiated and further studies can be taken up using clinical and resistant isolates furthering the investigation.
Keywords
Antiacne, impatiens walleriana Hook.f., Phytochemical, Hydroalcoholic extract, organisms, Ethnopharmacological
Introduction
A member of the "Balsaminaceae" family of ornamental plants, which has more than 1200 species scattered globally, is Impatiens walleriana. The plant Impatiens walleriana, sometimes known as "Busy Lizzy," thrives best in damp, humid environments. It includes phenolic substances, flavonoids, anthocyanins, steroids, and carbs, among other things. It is a garden plant that may be eaten, and traditional medicine uses it for its abortifacient, antibacterial, anticancer, and antioxidant properties [1] [2]. It is well known fact that several plants possess healing properties. Ethnopharmacological knowledge is useful tool to search and find species having bioactive potential and develop herbal remedies. The world health organization estimates that 65%-80% of world's population in developing countries prefer to use plants for their health care.There is an increasing resistance to antibiotics coupled with increased incidencesof ADRs to the current drugs used in treatment of Infections. [3] Native to the mountains of East Africa. Named "Sultana" after the Sultan of Zanzibar, it was first introduced in 1896 in the cold marshes of Zanzibar [4] Their apparent impatience to expel the ripe seeds, hence the botanical name 'impatiens', they are continuously blooming and often referred to as the 'busy lizzie'. It is naturalized throughout the world, including North America, Australia and the Pacific Islands, and grows in scrub along waterways. It grows in rich, moist soil and prefers shade. Impatiens grows up to 30-38 cm and has broad leaves, often alternating near the top of the plant. The flowers are abundant, with five petals and spores. Hybrid strains of impatiens plants have white, red, pink, orange, and sometimes bicolor flowers that are known to have one or more petals.The leaves can be oval or heart-shaped green. Sometimes there is a brown shield with red or brown spots underneath, [5] Impatiens have a variety of uses. It has bactericidal activity and reduces the problem of chemical control of fungal diseases in agriculture. [6] Using genetically modified toxic proteins delivered to mosquitoes through nectar, impatiens can be turned into a nectar plant that kills mosquitoes, which are known to live in a plant cage. [7] Toxic metal pollution in the environment has increased. Impatiens tend to concentrate heavy metals, such as lead, from the soil. [8] This aspect should be taken into account before exercising. Impatiens used in phytoremediation experiments have been shown to be effective in removing minerals from contaminated soil. [9] Its flowers are edible and have different flavors and colors depending on the variety. Impatiens (pink, sweet) is not toxic as no daily intake limits have been established.[10]Impatiens wallerianaHook.f. has both nutritional and therapeutic benefits in Brazilian traditional medicine. [10] Impatiens wallerianaHook.f. is used medicinally by the "Oromo" ethnic group, which is located in southern Ethiopia and the Bale are [11] In particular, the Oromo women utilize the roots to strengthen their hair. [12] In Africa, uterine infections are typically treated with impatiens walleriana Hook.f. [13] Amenorrhea and dysphagia are recognized conditions for therapy in Chinese medicine. [14] The root is dried and ground into "salep," a sweet-tasting, pungent-smelling powder that is used in cooking. It is nourishing and used to make drinks or as a cereal addition while making bread."Salep" relieves GI irritations since it is demulcent. A jelly made from "Salep" is used as a treatment for tension and stress in the mind. Impatience and irritation are reduced [15] You can add sweet-tasting edible flowers to salads or to upscale cocktails. Flowers that can be eaten contain 14.75 w/w Dry matter content, 4.60g/kg crude protein, fresh mass of phenolics and flavonoids, as well as elements such as phosphorus, potassium, calcium, magnesium, sodium, iron, manganese, copper, zinc, and molybdenum. As an abortifacient, liquid produced by crushing together water and dried roots and plants is consumed Pelargonidin. [16] complex 3:5-dimonoside is a pigment found in this plant's blooms; bluish rose blossoms specifically contain it.[17] Antibiotics that are more modern and secure are required.It is unknown whether Impatiens wallerianaHook.f. species have antibacterial properties. Because ethnopharmacological research reveals that it is effective in treating polymicrobial uterine infections, the current study has been undertaken. Acne, sometimes known as acne vulgaris, [18] is a common skin disorder characterized by oil glands located at the base of hair follicles. Acne is a skin illness. The growth of sebaceous (oil) glands typically occurs throughout puberty. Male hormones secreted by both male and female adrenal glands activate the aforementioned organs. Acne comes in this way. Acne vulgaris is a phrase for "common acne." It is a skin disease caused by sebaceous gland changes. The color is caused by an underlying ailment, in which the skin gets inflamed and changes color.Pimples are a common skin condition among adolescents. Acne is a common skin disorder that usually affects teenagers due to hormonal fluctuations. The best acne therapy depends on the severity of the disease, which can range from light (a few odd pimples) to moderate (inflammatory papules) to severe (nodules and cysts). Acne is a common condition during puberty. When a person matures from a child to an adult as a result of the release of several hormones. Acne is more common among people who reach maturity. Human skin contains pores (small openings) that link to the sebaceous glands situated beneath the skin. The glands are connected to the pores by follicles, which are tiny channels. These glands create sebum, an oily fluid that carries dead skin cells from the hair follicles to the skin's surface. A tiny hair grows through the hair follicle and out of the skin.Pimples form when these follicles get blocked, allowing oil to accumulate beneath the skin. Skin is made up of microscopic holes known as pores, which can become blocked with oil, debris, and bacteria, causing acne or "pimples" to appear. Under closed pores, oil accumulates. The bacteria on the skin is repeatedly affected by such a situation; acne may emerge, but it is not a life-threatening condition, however uncomfortable when severe. Acne is most commonly found on the face, neck, chest, back, and biceps. Chronic face acne can leave lifelong scars but is not hazardous.Multiple mechanisms occurring within the pilosebaceous unit lead to bacterial proliferation and inflammation, which is the etiology of acne.When changes in the body's hormonal environment affect the function of the pilosebaceous gland, this ailment often manifests around the time of the pubertal transition. Follicular epithelial cells initially develop improperly, form tighter intracellular adhesions, and are consequently less easily removed. This procedure causes the growth of hyperkeratotic plugs, also known as microcomedones, which gradually enlarge to produce non-inflammatory, closed or open comedones. [19] Circulating and cutaneously generated androgens, which are frequently cited as the main cause of acne, stimulate sebum production, which aids in the growth of comedones. [20]
MATERIALS AND METHODS:
Materials:
Table 1: List of chemicals and reagents used in the study

Equipment’s:
Table 2: List of Equipment used in the study

Magnetic stirrer:

Figure 1: Magnetic stirrer
Model: 1-MLH REMI ELEKTROTECHNIK LTD.
PRINCIPLE:
An external magnetic field is used by an electromechanical device called a magnetic stirrer to rotate a stir bar in a mixture. Up to one liter of material can be mixed by the stir bar, which spins at different speeds. Glass jars work well with magnetic stir bars. Comedone growth is aided by the production of sebum. [20]
Procedure:
Ensure that the working bench is clean, and stirrer speed control knob is in off position. Keepthe beaker containing 500ml solution of hydro-alcoholic mixture of each plant (I.W. & S.A.) on the centre of the magnetic stirrer. Switch on the power supply. It contains two knobs- one is Temperature controlling knob and another one is Stirring controlling knob.Rotate the stirring knob slowly to adjust the speed of rotation to 500-600nm, the bar magnet starts to rotate, magnetic bead also starts to rotate with the bar magnet. We have not used the temperature controlling knob because its cold maceration.After stirring is completed, decrease the stirring speed slowly by rotating the speed control knob anticlockwise and keep the knob in off position.Remove the magnetic bead.
Water bath evaporator:

Figure 2: Water Bath Evaporator
Model : WATER BATH RECTANGULAR
PRINCIPLE:
A water bath is an electromechanical device that helps to remove the alcoholic containts from extract, warming reagents, melting of substrates or incubation of cell cultures.
Procedure:
Water bath evaporator is an device that evaporates the alcoholic containts from the plant extract.
Fill the water bath with water, set the temperature at 300 c & turn on the start button and keep the extract on water bath to evaporate alcohol and water.
Collection of plant:
Impatiens walleriana Hook.f. flower-bearing plants were picked at random from a single garden source in Belagavi in the month of January 2016. For the investigation, the entire plan with the exception of the roots—was utilized. The specimen has been deposited in the RMRC herbarium with the accession number RMRC-1341 after being authenticated at the RMRC (Regional Medical Research Centre, Belagavi). Before being ground up with a mechanical grinder, the fresh plant material was sorted, cleaned to remove soil, and shade dried for two weeks.

Figure 3: Collection and drying of Impatiens walleriana
Extraction ofImpatiens walleriana
Maceration method
Fresh impatience walleriana leaves and stems were collected and cleaned with distilled water. The fresh leaves were dried and pulverized to a coarse powder. The coarse powder was steeped in a 50/50 ethanol/distilled water solution for three days. The mixture was then filtered via muslin cloth. The solvent in the extract was evaporated by keeping the temperature below 50 °C. The dried powder of impatience walleriana was stored in an airtight container. (Plan for standardization, extraction, and pre-phytochemical screening of herbal medications). Use 108g of powder with analytical grade hydroalcoholic as the solvent. The extraction process was then completed. [21] The dried powder of Impatiens walleriana was kept in an airtight container.

Fig 4: Extraction of Impatiens walleriana by maceration method
Percentage (%) yield:
The percentage (%) yield of hydroalcoholic extract of Impatiens wallerianais given below.[21].
Formula:
W2/W1×100
where,
W2 is the weight of extract against the container.
W1 is the weight of the container itself and
W0 is the weight of the dry powder used for extraction
Analysis of phytochemicals:
Preliminary tests with extract have been conducted to find the presence of phytoconstituents like carbohydrates, proteins, steroids, flavonoids, alkaloids, tannins, and phenolic compounds. [22]
Qualitative phytochemical analysis:
The extract was tested for the presence of bioactive compounds by using following standard methods.
Table 3:Qualitative phytochemical analysis of Impatiens walleriana

Antibacterial activity(Bacterial resistance):
By using the standard techniques outlined in the Manual of Clinical Microbiology of the research of 50 mg/ml, 100 mg/ml, and 200 mg/ml, a natural product diffusion method was employed to test the antibacterial activity.
Zone of Inhibition
Disc Diffusion Test Procedure
- Using a loop or swab, transfer the colonies to the plates.
- Visually adjust turbidity with broth to equal that of a 0.5 McFarland turbidity standard that has been vortexed. Alternatively, standardize the suspension with a photometric device.
Inoculation of Agar plate:
- Within 15 min of adjusting the inoculum to a McFarland 0.5 turbidity standard, dip a sterile cotton swab into the inoculum and rotate it against the wall of the tube above the liquid to remove excess inoculum.
- Swab entire surface of agar plate three times, rotating plates approximately 60º between streaking to ensure even distribution. Avoid hitting sides of petriplate and creating aerosols.
- Allow inoculated plate to stand for at least 3 minutes but no longer than 15 min before making wells.
Stock solution preparation:
- Prepare the stock solution weighing 10mg of compound and dissolve it in 1ml of DMSO
Addition of compound into plate:
- Take hollow tube of 5mm diameter, heat it. Press it on above inoculated Agar plate and remove it immediately by making a well in the plate. Likewise, make five well on each plate.
- With the help of micropipette add 50µl of each concentration in each well.
Incubation:
- Incubate plates within 15 min of compound application.
- Invert plates, and stack them no more than five high.
- Incubate for 18-24hrs at 37 ºC in incubator.
Reading plates:
- Read plates only if the lawn of growth is confluent or nearly confluent.
- Measure diameter of inhibition zone to nearest whole millimeter by holding the measuring device. [33]
RESULTS AND DISCUSSION:
Yield of extract:
Table 4: Percentage (%) yield of extract

Phytochemical studies:
Table 5: Test for presence of Phytochemicals in Impatiens walleriana plant extract


Antiacne activity:
Table 6: Zone of inhibition in millimeters obtained for the 3 concentration of impatiens walleriana extract.


Note:
S-Sensitive
R-Resistant
Standard Values
Erythromycin
Staph epidermidis-26mm

Figure 9: Antiacne Activity of Impatiens Walleriana and Erythromycin Estolate

Figure 10: Staphylococcus epidermidis susceptibility to the extract
DISCUSSION:
Results in Table.5 depict presence/absenceof phytoconstituents. Phytochemical studies on the whole plant extract got revealed for the very firsttime using the entire plant extract except root showed the presence of tannins, phenolics and flavonoids.Plants as such may provide alternate sources of antiacne agents with novel mechanisms and newtreatments.[34] As active principles are more soluble in alcohol, in the present studyextraction has been carried out using magnetic stirrer and hydroalcoholic employed as solvent. Results are as depicted in Table.6 wherein susceptibility alongwith the diameter ofthe zone of inhibition in comparison to the standard are mentioned. Findings confirmed antiacne potential asthe organism used in the study were sensitive to hydroalcoholic extract. Screening methods employed for natural products include disc diffusionmethods withdiffusion method variant "Disc" more suitable as it is simple and less time consuming. In the "Disc"variant natural product's diffusion by carriers like DMSO.[35] Hence, the study has beencarried out using the agar disc diffusion method. Acne is a common skin condition that affects the oil glands at the base of hair follicles. Skin illness known as acne. Acne is produced by a number of factors that occur within the pilosebaceous unit, including bacterial proliferation and inflammation. As a result, the study looked into the effectiveness of the hydroalcoholic extract against gram-positive organisms, which are known to cause acne and have ethnopharmacological properties. Impatiens walleriana extract is efficient against the anaerobic bacteria used in the study. The medicinal value of plants is derived from chemical components that have unique physiological actions. Previous research has found flavonoids, phenolics, proteins, and minerals in Impatiens walleriana flowers. Pigments are also reported in the flowers Constituents present in the whole plant of this species are not reported. In the present study extract has shown thepresence of proteins, flavonoids, tannins and phenolics. Phytochemicals like tannins exert antimicrobial activity by iron deprivation, hydrogen bounding or by non-specifically interacting with vital proteins/ enzymes, [36] Phenolics are known to cause membrane rupture and flavonoids much like tannins bind to enzymes, form complexes with the cell wall or bind to adhesions. [37] The antiacne activity of this extract may be due to the presence of either tannins/ phenolics/ flavonoids or is due to the synergistic effect of these constituents. Since bacterial growth inhibition does not mean bacterial death, the method used does not distinguish bactericidal and bacteriostatic effects.
CONCLUSION
The study investigated the antiacne properties of Impatiens walleriana using a hydroalcoholic extract. The results confirmed the plant’s antiacne potential against gram-positive organisms, as demonstrated by significant zones of inhibition in the disc diffusion method. Phytochemical analysis revealed the presence of flavonoids, phenolics, proteins, and tannins, which are known to possess antimicrobial properties. The antiacne activity could be attributed to these constituents, either individually or through synergistic effects. The findings support the ethnopharmacological use of Impatiens walleriana in treating acne, suggesting it as a promising alternative source of antiacne agents. Further studies, including clinical trials and research on drug-resistant bacterial strains, are recommended to substantiate these results.
ACKNOWLEDGMENT:
Authors would like to express my sincere gratitude towards beloved Principal, Guide, Faculty members and non-teaching staff of department of pharmaceutics, Rani chennamma college of pharmacy Belagavi. For providing necessary facilities to carry out this project work.
REFERENCE
- Conde BS, Rogerio ITS, Siqueira AM, Ferreira MQ, Chedier LM, Pimenta DS. Ethnopharmacology in the vicinity of the botanical garden of Federal University of Juiz de Fora, Brazil. Ethnobot. Res. Appl. 2014; 12: 91-111.
- Haider F, Ullah N. Antioxidant and antimicrobial activity of Impatiens walleriana local to Malaysia. Moroccan Journal of Chemistry. 2019 Aug 2;7(3):J-Chem.
- Otto RBD, Ameso S, Onegi B. Assessment of antibacterial activity of crude leaf and root extracts of Cassia alataagainst Neisseria gonorrhea. African Health Sciences 2014; 14(4): 840-847.
- Perry L. Plant Lore the African Violet and fimpatiens. The Green Mountain Gardenes [ News article] 12 screens)- Available from: URL: http://www.avm.edu/pss/ppp/articles/african.html
- Plants & Flowers Comprehensive plants & flowers database. Available from: www.plantirescue.com/impatiens-walleriana
- Domingues RJ, Souza JDF, Tofoli JG, Matheus DR Action"in vitro" of plant extracts on Collettrichumacufatum, Alternaria solani and Sclerotium roll. Arg. Inst. Biol. 76(4): 643-649.
- Kearney C. Chen Z. Mosquitocidal Nectar Delivery: Evaluation of candidate plant species in Abstract Book 63rdAnnual Meeting?November 2-6, Supplement to American Society of Tropical Medicine & hygiene 2014, 91(5):47.
- Naeem 1, Taskeen A. Arif N, Mubeen H. Evaluation of metal pollution in medicinal plants. Researcher 2009, 1(4) 42-49.
- Schenato, Flavia, Schroder, Nadia T, Martins, Flavia B. Assessment of contaminated soils by heavy metals immunicipal solid waste landfills in southern Brazil, WSEAS transactions on environment and development 20084(9): 745-755.
- Rep O, Micek J, Jurikova T. Neugebauerova J, Vabkova J. Edible flowers- A new promising source of mineralelements in human nutrition. Molecules 2012, 17: 6672-6683.
- Fernandes MJB, Barros AV, Melo MS, Sumoni IC. Screening of Brazilian plants for antiviral activity against animal herpesviruses. J. Med. Plants. Res 2012; 6(12): 2261-2265.
- Rainer WB, Paul S, Aserat W, Paul E. Planit use in Odo-Bulu and Demaro, Bale region, Ethiopia. J. EthnobiolEthnomedicine 2011, 7(28): 1-50.
- Conde BE, Siqueira AM, Rogerio ITS, Marques JS, Bercard GG, Ferreira MQ, Chedier LM, Pimenta DS. Synergyin ethnopharmacological data collection methods employed for communities adjacent to urban forest. Rev BramFarmacogn 2014, 24:425-432.
- Lopes RK, Ritter MK, Rates SMK. Review of biological activity and toxicity of omamental plants most used in Ric Grande do Sul, Brazil Braz. J. Biol. Sci. 2009; 7: 305-315.
- A hobby blog for educational purpose. Find Me A Cure: Alternative Medicine. Available from: URL: http:// findmencure.com/tag/Africa
- Lim TK. Edible Medicinal And Non-Medicinal Plants, Flowers Springer Sciences Business Media Dordrech 2014, 7:543-550.
- Raw Materials Weald of India CSIR New Delhi 2010; V(H-K) 22.
- Strauss JS., Krowchuk DP., Leyden JJ., et al, Guidelines of care for acne vulgaris management, American Academy of Dermatology/American Academy of Dermatology Association, J Am Acad Dermatol, 2007; 56:4: 651-663.
- Brown SK, Shalita A. Acne vulgaris. Lancet 1998; 351(9119):1871–6
- Chen W, Thibouot D, Zouboulis CC. Cutaneous androgen metabolism: basic research and clinical perspectives. J Invest Dermatol 2002;119(5): 992–1007.
- Anokwuru CP, Anyasor GN, Ajibaye O, Fakoya O and Okebugwu P. Effect of extraction solvents on phenolic, flavanoid and antioxidant activities of three Nigerian medicinal plants. Nature and Science 2011; 9(7): 53-61.
- Khandelwal KR. Preliminary phytochemical screening in Practical Pharmacognosy Techniques & Experiments 19 edition Nirali prakashan 2008; 149-156.
- Raaman N. Phytochemical Techniques. New India Publishing Agency, New Delhi, 2006, 19-24.
- Singh V, Kumar R. Study of Phytochemical Analysis and Antioxidant Activity of Allium sativum of Bundelkhand Region. International Journal of Life Sciences Scientific Research. 2017; 3(6):1451-1458.
- Silva GO, Abeysundara AT, Aponso MM. Extraction methods, qualitative and quantitative techniques for screening of phytochemicals from plants. American Journal of Essential Oils and Natural Products. 2017; 5(2):29-32.
- Tiwari P, Kumar B, Kaur M, Kaur G, Kaur H. Phytochemical screening and Extraction: A Review. Internationale Pharmaceutica Sciencia. 2011; 1(1):98- 106.
- Auwal MS, Saka S, Mairiga IA, Sanda KA, Shuaibu A and Ibrahim A. Preliminary phytochemical and elemental analysis of aqueous and fractionated pod extracts of Acacia nilotica (Thorn mimosa). Veterinary Research Forum. 2014; 5(2):95-100.
- Nanna RS, Banala M, Pamulaparthi A, Kurra A, Kagithoju S. Evaluation of Phytochemicals and Fluorescent Analysis of Seed and Leaf Extracts of Cajanus cajan L. International Journal of Pharmaceutical Sciences Review and Research. 2013; 22(1):11-18.
- Tyagi T. Phytochemical Screening of Active Metabolites Present in Eichhornia Crassipes (Mart.) Solms and Pistia stratiotes (L.): Role in Ethanomedicine. Asian Journal of Pharmaceutical Education and Research. 2017; 6(4):40- 56.
- Bhandary SK, Bhat VS, Sharmila KP, Bekal MP. Preliminary phytochemical screening of various extracts of Punica granatum peel, whole fruit and seeds. Journal of Health and Allied Sciences NU. 2012 Dec;2(04):34-8.
- Savithramma N, Rao ML, Suhrulatha D. Screening of Medicinal Plants for Secondary Metabolites. Middle-East Journal of Scientific Research. 2011; 8(3):579-584.
- Shalini S, Sampathkumar P. Phytochemical screening and antimicrobial activity of plant extracts for disease management. International Journal of Current Science. 2012;1(1):209-18.
- Isenberg HD. Disc diffusion procedure. Clinical microbiology procedures handbook American society for microbiology/ Washington DC 1992; Part 2: 5.1.29
- Arullappan S, Zakaria Z, Basri DF. Preliminary screening of antibacterial activity using crude extracts of Hibiscus rosa sinensis. Trop. Life Sci. Res. 2009; 20(2): 109-118.
- Valgas C, De Souza SM, Smania EFA, Smania Jr A. Screening methods to determine antibacterial activity of natural products. Braz J. Microbiol. 2007; 38: 369-380.
- Rajendran R, Manikandan A, Hemalatha K, Prabhavathi P, Karthik SS. Efficiency of Impatiens Balsamina extracts for antimicrobial activity. A Journal of Science and Technology 2014; 2(1): 60-64.
- Chaouche T, Bekkara F. Haddouchi F. Boucherit Z. Antibacterial activity of different extract of Echiumpycnanthum pommel. J. Chem. Pharm. Res 2012; 4(1): 216-220.


 Vani Chatter*
Vani Chatter*
 Rashmita Akkatangerhal
Rashmita Akkatangerhal
 Mouzama Tashewale
Mouzama Tashewale

10.5281/zenodo.13972404
10.5281/zenodo.13972404